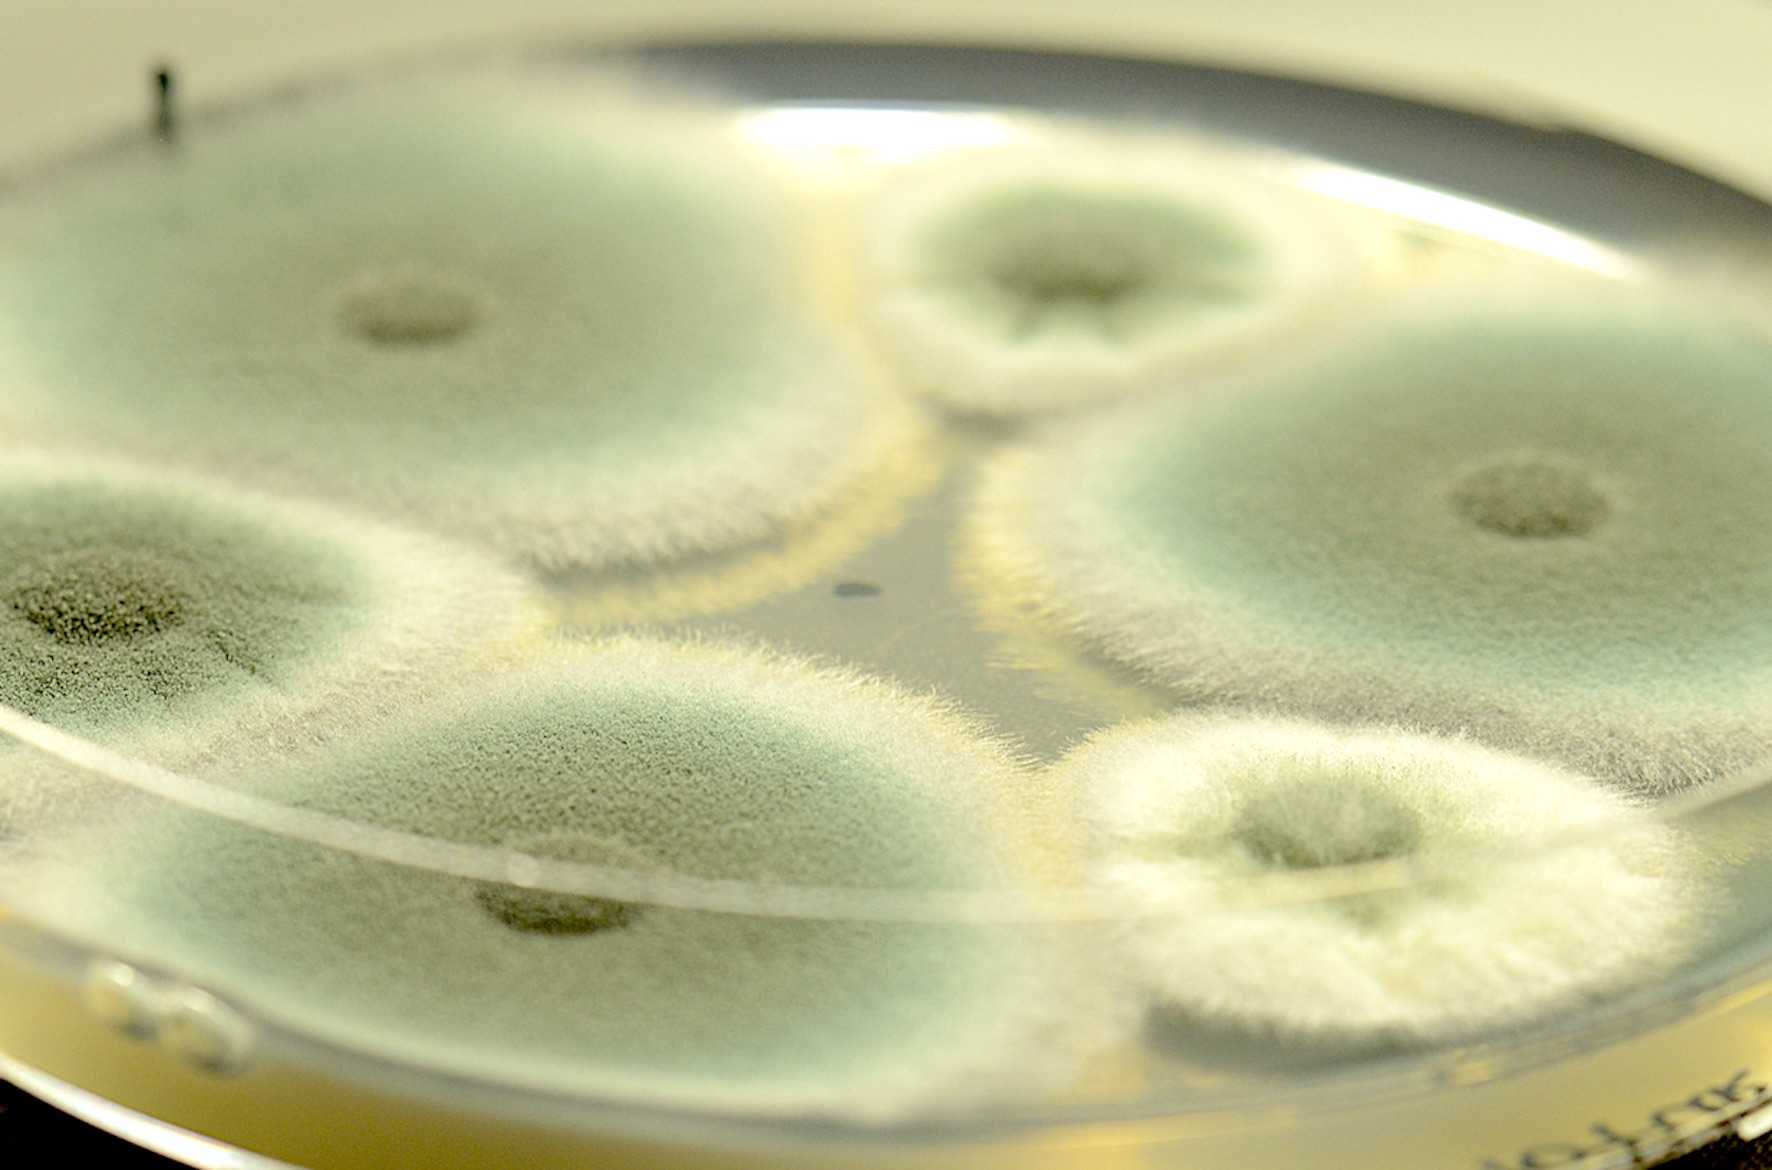

Antifungal Therapeutics and Resistance

Fabio Gsaller
phone: +43/512/9003-70224
email: fabio.gsaller[at]i-med.ac.at
Group members
CV
Annually, more than 1.5 million people die as result of fungal infections. Around one third of deaths are caused by the genus Aspergillus, in particular, the major human mold pathogen Aspergillus fumigatus.
Fungi as well as mammals belong to the domain of eukaryotes and vital processes in mammalian cells are also conserved in fungal species. Therefore, substances with antifungal activity often have toxic effects on human cells, which makes it particularly challenging to develop novel antifungal drugs. The current therapeutic arsenal to treat fungal infections only comprises four classes of antifungal agents: azoles, polyenes, echinocandins and nucleobase analogs. The treatment of choice for Aspergillus infections consists of azole based antifungals, however, emerging resistance to clinically administered azole drugs represents a growing threat to human health.
Our research focuses on the molecular investigation of antifungal drug mechanisms of action and to elucidate factors that contribute to antifungal resistance. We aim to acquire a more comprehensive understanding on the metabolic effects of antifungals as well as on the adaptive strategies employed by A. fumigatus to protect itself from antifungal compounds with the final goal to develop alternative strategies to treat fungal diseases.
An additional research goal is the development and improvement of molecular tools to enhance molecular analysis of fungi.

Publications



